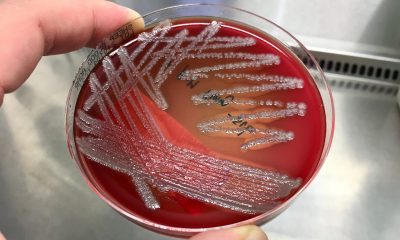
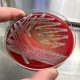

Cel mai mare depozit de anvelope uzate din lume, localizat în Al Sulaibiya, Kuwait, a luat foc, iar incendiul este vizibil din satelit. Potrivit Știrile Pro...


PARADISE TRAVEL SRL anunță lansarea proiectul cu titlul „PARADISE TRAVEL SRL” proiect nr RUE M2-11099 înscris în cadrul Măsurii ”Granturi pentru capital de lucru”, instituită prin...


Eugen Stan, fostul agent al Brigăzii de Poliție Rutieră cunoscut publicului drept „polițistul pedofil” după ce a agresat sexual nu mai puțin de 18 persoane, între...


Valurile de căldură care afectează foarte multe regiuni ale lumii, inclusiv România, au impus o nouă sintagmă – ”domul de căldură”. Acest fenomen aduce temperaturi de...


Trei persoane au fost ucise și alte zeci rănite, în timp ce două trenuri de călători s-au ciocnit miercuri în sud-vestul Republicii Cehe. Accidentul a avut...


Jay Pickett, un cunoscut actor de la Hollywood, a murit în timp ce se afla pe platoul de filmare. Actorul avea 60 de ani și ar...


Angajatorii înregistrați pe platforma de recrutare online BestJobbs au contactat de trei ori mai mulți candidați pentru posturile scoase pe piață, iar angajații au depus mai...

Cercetătorii bulgari au descoperit o bacterie patogenă care poate îmbolnăvi peștii, dar și oamenii. Aceasta poate duce tumori şi hemoragii interne. Ea este o Pseudomonas, a...


Ministerul Afacerilor Externe a emis o atenționare de călătorie pentru Spania, vizându-i pe cetățenii care se află sau urmează să tranziteze ori să se deplaseze în...


Co-preşedintele USR PLUS, Dacian Cioloş, a declarat, marţi seară, că premierul nu i-a solicitat concret ministrului Transporturilor, Cătălin Drulă, să îl dea afară pe directorul CFR,...


Un preot britanic și-a cusut buzele, pentru a protesta împotriva „suprimării informațiilor științifice” despre schimbările climatice din media deținute de magnatul Rupert Murdoch, relatează Euronews. Reverendul...


Horoscopul zilei de 4 august 2021, realizat de astrologul Mădălina Manole, vine cu previziuni astrologice și sfaturi pentru toate zodiile, în dragoste, carieră, bani și sănătate....


Un preot britanic și-a cusut buzele, pentru a protesta împotriva „suprimării informațiilor științifice” despre schimbările climatice din media deținute de magnatul Rupert Murdoch, relatează Euronews. Reverendul...


Antena 3 a adresat Ministerului Sănătății 7 întrebări legate de siguranța și eficacitatea vaccinurilor anti-Covid, dar și despre campania de vaccinare. 1. Există o strategie națională...